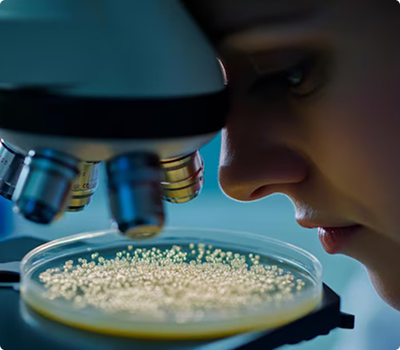

Our process begins with the careful selection of premium paddy from trusted local farms in and around Gwalior. We work closely with farmers to ensure that the paddy is harvested at its optimal maturity, preserving its natural flavor and nutritional value. Traditional knowledge combined with modern agricultural practices ensures a bountiful and high-quality yield.

India is the largest exporter
of rice in the World.
Rice is primarily composed of carbohydrate, which makes up almost 80%Trusted Source of its total dry weight. Most of the carbohydrate in rice is starch. Starch...
Read More
India is the largest exporter
of rice in the World.
Rice is primarily composed of carbohydrate, which makes up almost 80%Trusted Source of its total dry weight. Most of the carbohydrate in rice is starch. Starch...
Read More